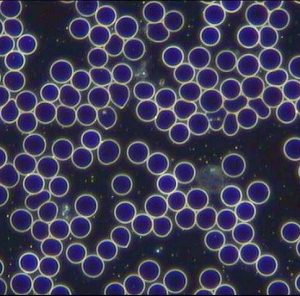
Blutzellen

„Gesundheit ist nicht alles, aber ohne Gesundheit ist alles nichts“.
Arthur Schopenhauer
Das Wohlfühl – Konzept:
Premium Magnetfeldtherapie-
System: Magnetek Professional®
Für Klinik, Praxis oder den anspruchsvollen Heimanwender
Wir sind AUTORISIERTER Fachhändler und Montag bis Samstag für Sie telefonisch persönlich erreichbar.
Das Wohlfühlkonzept (mit umfassendem Frequenzgang und Schumann-Resonanz)
Die Vorzüge des Magnetek Professional -aktuelles Modell- auf einen Blick :
- Aus Sicherheitsgründen wird das Gerät in Deutschland gefertigt: Made in Germany
- 2 Jahre Garantie, Beratungsservice über die Garantiezeit hinaus
- Qualität: Hochwertige Präzisionsarbeit auf Profi Niveau
- Umfassender Frequenzgang (Wide Frequency Range) bis 250 Hz für deutlich effizientere Anwendungen
- inklusive der Schumann-Resonanzfrequenz (n. Prof. Winfried Otto Schumann TU München)
- umfangreiches Entspannungs- und Nachtprogramm

- zusätzliche Ausstattungmerkmale:
- 3 großflächige Magnetfeldspulen (3 Segmente), faltbarer Applikator
- Praktikable Größe (vgl. Kissen), gefaltet, gut transportabel
- Praktisches Scanprogramm für die Vielfalt unterschiedlichster Strukturen
- Zielgenauer Einsatz durch manuell einstellbare Frequenzen von 1 Hz bis 250Hz in unterschiedlichen Schritten
- Organrelevante Resonanzfrequenzen
- 7 Automatikprogramme mit verschiedenen Frequenzdurchläufen für differenzierte Anwendungen
- 5-stufige Intensitätseinstellung
- Individuelle Anpassung, auch für sensitive Anwender
- Manuelle Einstellung der Anwendungsdauer möglich
- Vermeidung von Gewöhnungs -und Toleranzeffekten durch spezifische Programme
- Bipolar gepulstes Magnetfeld
- Stromsparende Standby-Funktion
- Hohe Sicherheit durch 18 V-Kleinspannung
- Komfortables Handbedienteil mit Hintergrundbeleuchtung (austauschbar)
- Schadstoffgeprüfte Materialien, leicht desinfizierbarer Bezug
- Anschmiegsames Produkt durch weichen Schaumkern
- Lieferumfang INKLUSIVE Herz-Waage-Kissen und ergonomischem Nackenkissen
- Update- und Upgradefähig
- Maße, ausgelegt ca. L180 cm x B45cm x T3cm


„Das Gute bewahren und den Fortschritt erkennen“
Expertentipp: Magnetek Professional mit 1 Hz bis zu 250 Hz für deutlich effizientere Anwendungen – auch für sensitive Nutzer

Inkusive Schumannresonanz- und Nacht-Programm

Automatikprogramme :
- P1 : Frequenzen 10 – 70 Hz
- P2 : Frequenzen 4 – 60 Hz
- P3 : Frequenzen 1 – 6 Hz
- P4 : Frequenzen 7 – 11 Hz (Schumannfrequenzen)
- P5 : Frequenzen 2 – 25 Hz
- P6 : Frequenzen 10 – 250 Hz
Auch als Nachtprogramm während des Schlafens mit langer Anwendungszeit nutzbar - P7 : Frequenzen 10 – 30 Hz
Technische Daten des Magnetek Professional® :
Netzteil
100 – 240 V AC / 50 – 60 Hz
Ausgang 18 V DC / 3610 mA
Nennaufnahme 65 W
Gewicht
Brutto ca 2,8 kg
Hinweise zu Kontraindikationen: siehe unten
Hier laden Sie den Flyer herunter
Albert Einstein: „Die Medizin der Zukunft ist die Medizin der Frequenzen“

Angenehm einfache Bedienung: Die MAGNETEK-Steuereinheit ( Maße ca. 15 x 6 cm)


Preis inklusive 19% MwSt. und Versand frei Haus : € 2.290,-
Autorisierter Fachhändler
========================================================================================================
Literaturempfehlung:
Studienbuch Magnetfeldtherapie
von Dr. Christian Thuile
ISBN 2-03738-131-0

Rote Blutkörperchen (hier: frei von Verklumpungen)

______________________________________________________________________________
Litaraturempfehlungen zu den Themen Resilienz, Burnout-Prävention und Schmerztherapie
von Dr. Markus A. Kulbe
ISBN 978-3981033304

ISBN 978-3981033328
Mindspectrum Verlag für Gesundheit, Psychologie und Kommunikation
========================================================================================================
Separater -3D mat-Intensivapplikator (Abb. ähnlich)

__________________________________
Separater Biolight -Applikator (Abb. ähnlich)
-Niederfrequenz Lichttechnologie

__________________________________________________________
MagHelios
Nutzen Sie die Kombination aus Ganzkörper- und Lokalanwendung
(Abb. ähnlich)


MagSignum
1 Ganzkörpermatte, 1 sep. 3D- Intensivapplikator, 1 TENS-/EMS-Gerät, 1 Lichtdusche 10.000 Lux

MagBiolight
1 Ganzkörpermatte, 1 sep. 3D-mat Intensivapplikator, 1 TENS-/EMS-Gerät, 1 Lichtdusche 10.000 Lux und
1 Softlaser-Dusche

Mag 3-D Platinum
1 Ganzkörpermatte, 1 sep. 3D Intense Ringapplikator, 1 TENS-/EMS-Profi Koffer und 1 Lichtdusche 10.000 Lux

MagFlex
1 Ganzkörpermatte, 1 sep. Gurtapplikator, 1 TENS-/EMS-Gerät und 1 Lichtdusche 10.000 Lux

Hier geht es zur Bestellung
OPTIONALE ERGÄNZUNGEN : Abb. ähnlich
sep. 3D-mat Intensivapplikator
TENS-Gerät im Koffer
Separater Schallwellen-PEMF-Applikator

Sep. Ringapplikator

Sep. Gurtapplikator

MultiMag
Pulsierendes Magnetfeldtherapiesystem für Praxis und Privat
Ganzkörperapplikator ca. 192 x 79 cm (Abb. ähnlich, lieferbar in dkl.blau) und Lokalapplikator mit zusätzlichem gepulsten Licht
Großer Frequenzgang ( Grundfrequenzen bis 100 Hertz )
4 exakt abgestimmte Intensivprogramme oder manuelle Frequenzeinstellung
Multifunktionalität : gleichzeitige Nutzbarkeit beider Applikatoren
Komfortable Handbedienung
ZUSÄTZLICH :
TENS-Gerät und Lichtdusche 10.000 Lux
Preis : 1.890,00 €
MultiMag Intense
wie MultiMag,
zusätzlich mit Softlaser-Dusche
Preis : 2.190,00 €

Abb. ähnlich, lieferbar in dkl.blau

Preise jeweils inklusive 19% MwSt. und Versand frei Haus !
ACHTUNG
Die Anwendung von Magnetfeldtherapie ersetzt nicht die ärztliche Behandlung. Bitte klären Sie die Anwendung mit Ihrem Arzt ab.
Bei folgenden Kontraindikationen darf Magnetfeldtherapie nicht angewandt werden: Schwangerschaft; Epilepsie; Herzschrittmachern und anderen elektronischen Implantaten; akuten, fieberhaften Pilz- und Bakterien-Infektionen; schweren Herzrhythmusstörungen; starkem Blutverlust.

